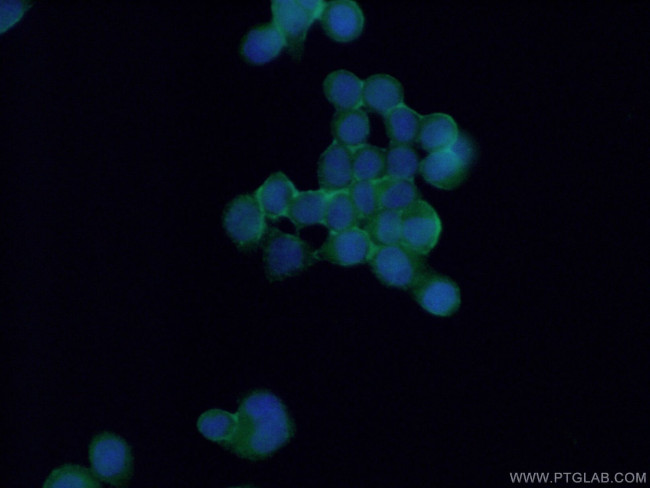
P2RX5 Antibody in Immunocytochemistry (ICC/IF)

Search
Proteintech
P2RX5 Polyclonal Antibody
{{$productOrderCtrl.translations['antibody.pdp.commerceCard.promotion.promotions']}}
{{$productOrderCtrl.translations['antibody.pdp.commerceCard.promotion.viewpromo']}}
{{$productOrderCtrl.translations['antibody.pdp.commerceCard.promotion.promocode']}}: {{promo.promoCode}} {{promo.promoTitle}} {{promo.promoDescription}}. {{$productOrderCtrl.translations['antibody.pdp.commerceCard.promotion.learnmore']}}





Please note: We are reviewing Western blot images included in the antibody testing data in our catalog, including those provided by third parties. Unless expressly labeled or annotated as “raw-unedited”, Western blot images included in the antibody testing data in our catalog may have been edited, optimized or otherwise adjusted for presentation.
产品信息
19012-1-AP
种属反应
已发表种属
宿主/亚型
分类
类型
抗原
偶联物
形式
浓度
规格
纯化类型
保存液
内含物
保存条件
运输条件
产品详细信息
Immunogen sequence: KKGYQDVDT SLQSAVITKV KGVAFTNTSD LGQRIWDVAD YVIPAQGENV FFVVTNLIVT PNQRQNVCAE NEGIPDGACS KDSDCHAGEA VTAGNGVKTG RCLRRENLAR GTCEIFAWCP LETSSRPEEP FLKEAEDFTI FIKNHIRFPK FNFSKSNVMD VKDRSFLKSC HFGPKNHYCP IFRLGSVIRW AGSDFQDIAL EGGVIGINIE WNCDLDKAAS ECHPHYSFSR LDNKLSKSVS SGYNFRFARY YRDAAGVEFR TLMKAYGIRF DVMVNGKGAF FCDLVLIYLI KKREFYRDKK YEEVRGLEDS SQEAEDEASG LGLSEQLTSG PGLLGMPEQQ ELQEPPEAKR GSSSQKGNGS VCPQLLEPHR ST (52-422 aa encoded by BC039015)
靶标信息
The P2X5 gene encodes a protein that is a member of the purinergic receptor family, P2X receptors. These receptors are ligand-gated ion channels activated by extracellular ATP. The P2X5 protein is primarily involved in the regulation of skeletal muscle, immune response, and sensory neuron functions. Structurally, P2X5 features two transmembrane domains, a large extracellular loop, and intracellular N- and C-termini. P2X5 is known to form both homomeric and heteromeric channels, contributing to its functional diversity in various tissues.
仅用于科研。不用于诊断过程。未经明确授权不得转售。
生物信息学
蛋白别名: ATP receptor; MGC47755; P2X purinoceptor 5; P2X5; Purinergic receptor
基因别名: P2RX5; P2X5; P2X5FL
Entrez Gene ID: (Human) 5026